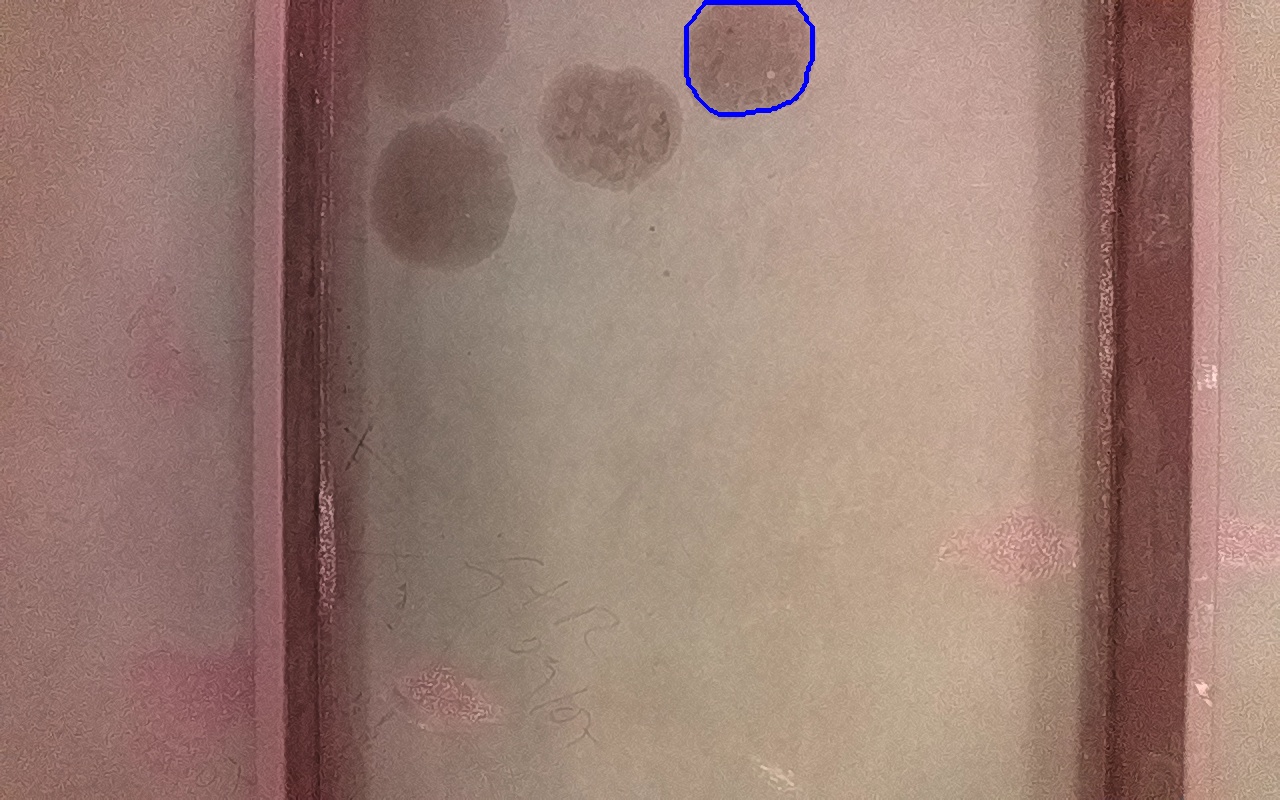

Discontinuidad detectada
| Tipo |
IV-2
Marcas de aceite o grasa. Suciedades o todo tipo de contaminantes solubles. |
|---|---|
| Fecha | 26/06/2025 13:22 |
| Tamaño (mm) | 7851 mm2 |
| Tamaño (m) | 0.0079 m2 |
| Confianza | 87.29 % |
| Posición |
X: 2.87 Y: -0.21 Z: 0.02 |
| Resultado |
Convertido en dicsontinuidad final: 265215 |